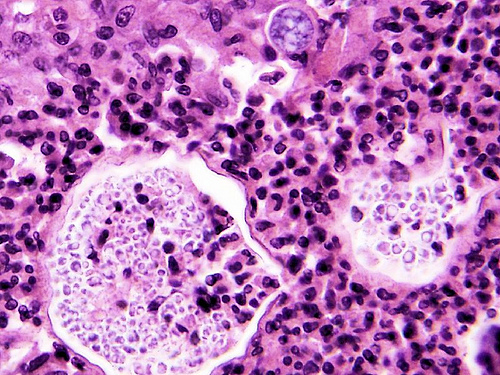
腦膜炎群聚感染 多名學生住院觀察

A型流感症狀2016

進入流行感冒季節,每個爸媽都擔心自己家中的寶貝被傳染了,那要如何從日常生活跟食物來預防流感呢?
閱讀更多媽媽育兒百科 / 健康知識網 / 生活智慧王
收集各種大大小小的健康知識、常識,讓我們能更了解如何保持身體的健康。

進入流行感冒季節,每個爸媽都擔心自己家中的寶貝被傳染了,那要如何從日常生活跟食物來預防流感呢?
閱讀更多
像春節、中秋等重要假期,家家戶戶都會享用豐盛的美食大餐。吃得油膩、運動量少不少人出現消化不良、腹瀉等不適症狀。那麼,像這種重要節日該怎樣排油解膩呢?
閱讀更多![[新聞稿]女子國外旅遊染德國麻疹 民眾前往流行地區應先接種疫苗 [新聞稿]女子國外旅遊染德國麻疹 民眾前往流行地區應先接種疫苗](https://mamibabe.com/wp-content/uploads/2016/01/9401187151_f7612227af_b.jpg)
疾病管制署公布今(2016)年首例德國麻疹確定病例,為北部39歲女性,本(1)月18日因皮膚多處出疹就醫,由於症狀未改善,且出現發燒、咳嗽、頸部淋巴腺腫大等情形,於20日再度就醫,經檢驗確認感染德國麻疹,目前個案健康情形良好並已解除隔離;由於其在暴露期間均於香港自助旅遊,研判為境外移入病例。提醒民眾農曆年節將至,如規劃出國旅遊、探親務必做好個人防護並留意健康狀況,如有不適症狀請儘速就醫,以降低感染疫病的風險。
閱讀更多
春節將至,暴飲暴食導致腸胃疾病的患者也增多,如何大吃大喝又能照顧腸胃呢?
閱讀更多
最近疾管署發現國內有首例境外移入茲卡病毒(Zika)的感染個案,是一名泰籍男性在入境時被發燒篩檢站攔下,經血液檢體檢驗後確認感染,目前據了解,該疾病與新生兒小頭畸形症有關,所以不得輕忽,而茲卡病毒是經由蚊蟲叮咬為主要傳染途徑,懷孕婦女應避免前往中南美與加勒比海地區及東南亞六國旅遊,也要特別留意當心防蚊。
閱讀更多
疾病管制署公布新增1例腸病毒重症確定病例,為北部剛滿月女嬰,所幸經治療後病況穩定。疾管署呼籲,目前社區中仍有腸病毒疫情流行,學齡前嬰幼兒為重症高危險群,家長及照顧者應特別注意個人衛生習慣及防護措施,並留意嬰幼兒健康情形,以避免因感染腸病毒引發重症。
閱讀更多![[新聞稿]流感疫情升溫,有症狀及早就醫遵醫囑用藥,降低重症風險 [新聞稿]流感疫情升溫,有症狀及早就醫遵醫囑用藥,降低重症風險](https://mamibabe.com/wp-content/uploads/2016/01/22527047703_a0eedd96c2_b.jpg)
氣候轉冷,流感疫情持續上升,疾管署呼籲,民眾如尚未接種流感疫苗請儘速接種,如出現類流感症狀或流感危險徵兆應儘速就醫;另請醫師提高警覺,對於符合公費流感抗病毒藥劑用藥條件的患者應及早給藥,以降低流感併發重症發生的風險。
閱讀更多
今天看到一則新聞有關嘉義一所國中發現有十幾位國中生發生頭痛、嘔吐與發燒等情形,經診斷發現為高傳染性病毒腦膜炎,這是近年來大型的群聚感染的案例,家長們可不能輕忽,尤其發現孩子有類似感冒或腸胃道引起的症狀時,千萬要特別留意。
閱讀更多
大家都會希望自已與身邊的親友能健康長命,而澳洲雪梨大學對於超過23萬名45歲以上澳洲人進行長達六年的研究,發現有六種不良習慣會提高早死的風險,大家可以檢視一下自已是否有這六種習慣呢?
閱讀更多
疾管署近期所寄發的「104年版兒童健康手冊」有關「預防接種時程紀錄表」中之A型肝炎疫苗第1、2劑接種間隔應「隔6個月」誤繕為「隔6週」,請新領到兒童健康手冊的拔拔麻麻們要注意一下唷。
閱讀更多